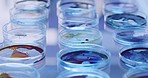
Closeup of a syringe and glass plate or petri dishes with colorful samples on a table in a research lab. Medical biologist using glassware for virus testing and growing bacteria in a laboratory

Stock Photo - Scientist using virtual reality goggles to examine diagnosis experiment in 3D while working in laboratory. Pathologist and biochemical engineer using vr metaverse technology to explore DNA genetics
Scientist using VR virtual reality goggles to examine diagnosis experiment in 3D while working in a laboratory. Pathologist and biochemical engineer using metaverse technology to explore DNA genetics - Stock Photo
Stock photo ID: 2545848
Stock Photo Keywords:
working pathologist lab scientist virtual genetics dna biochemical experiment reality goggles genetic examine engineer laboratory chemical technology vr
How do you plan to use this image?
Choose Size and Download